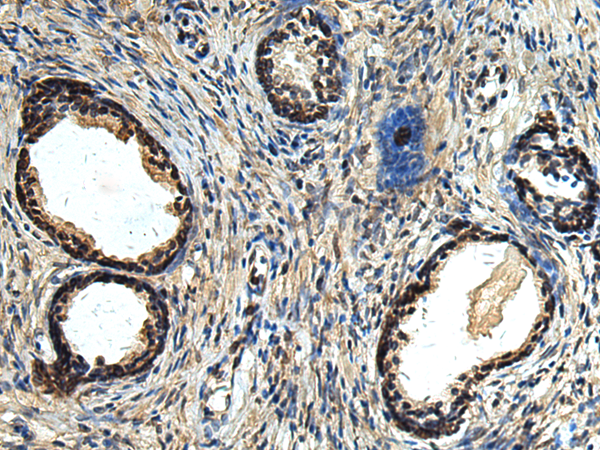

|
Background: |
The protein encoded by this gene is part of a protein complex that mediates degradation of inositol 1,4,5-trisphosphate receptors in the endoplasmic reticulum. The encoded protein also binds cholesterol and regulates the SREBP signaling pathway, which promotes cellular cholesterol homeostasis. Defects in this gene have been associated with spastic paraplegia 62. |
|
Applications: |
ELISA, WB, IHC |
|
Name of antibody: |
ERLIN1 |
|
Immunogen: |
Fusion protein of human ERLIN1 |
|
Full name: |
ER lipid raft associated 1 |
|
Synonyms: |
KE04; KEO4; SPFH1; SPG62; Erlin-1; C10orf69 |
|
SwissProt: |
O75477 |
|
ELISA Recommended dilution: |
5000-10000 |
|
IHC positive control: |
Human tonsil and Human prostate cancer |
|
IHC Recommend dilution: |
50-200 |
|
WB Predicted band size: |
39 kDa |
|
WB Positive control: |
Rat pancreas tissue lysate |
|
WB Recommended dilution: |
500-2000 |

購(gòu)物車
購(gòu)物車 幫助
幫助
 021-54845833/15800441009
021-54845833/15800441009
